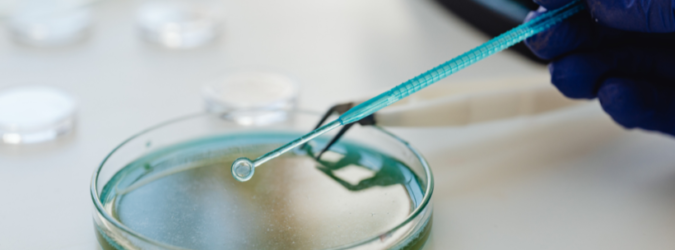
Super batterio di 5mila anni

È rimasto intrappolato nel ghiaccio per circa cinquemila anni, ma oggi mostra una sorprendente resistenza a dieci antibiotici moderni. La scoperta arriva dalla Romania, dove un team di ricercatori guidato dall’Istituto di Biologia di Bucarest dell’Accademia Rumena ha isolato un antico microrganismo nella celebre grotta ghiacciata di Scărișoara.
Super batterio di 5mila anni scoperto in Romania: resistente a 10 antibiotici
Il ritrovamento è avvenuto nella Grotta di Scărișoara, uno dei più grandi ghiacciai sotterranei d’Europa, situato nei Monti Apuseni. Qui, in strati di ghiaccio risalenti a circa 5.000 anni fa, è stato isolato un ceppo appartenente al genere Psychrobacter, microrganismi noti per la capacità di sopravvivere e proliferare a temperature estremamente basse.
Lo studio, pubblicato sulla rivista scientifica Frontiers in Microbiology, evidenzia che il batterio risulta resistente a 10 dei 28 antibiotici testati in laboratorio, tra cui diversi ampiamente utilizzati nella pratica clinica moderna.
Le analisi genetiche hanno individuato oltre 100 geni associati alla resistenza agli antibiotici e circa 600 geni la cui funzione è ancora sconosciuta. Un patrimonio genetico che dimostra come i meccanismi di difesa batterica siano molto più antichi dell’uso clinico degli antibiotici, introdotti solo nel XX secolo.
Una minaccia globale ma anche una possibile opportunità
La scoperta si inserisce nel contesto dell’antibiotico-resistenza, considerata una delle principali emergenze sanitarie globali e responsabile di oltre 35mila decessi l’anno in Europa.
Secondo i ricercatori coordinati da Cristina Purcarea, ceppi simili rappresentano un’arma a doppio taglio. Da un lato, lo scioglimento dei ghiacci dovuto ai cambiamenti climatici potrebbe liberare microrganismi antichi, favorendo la diffusione dei loro geni di resistenza nei batteri contemporanei e aggravando ulteriormente il problema.
Dall’altro lato, lo stesso microrganismo produce 11 geni contenenti istruzioni per la sintesi di enzimi e composti antimicrobici potenzialmente capaci di bloccare o distruggere altri batteri, virus e funghi. Proprio questi enzimi potrebbero ispirare nuove strategie terapeutiche e la messa a punto di antibiotici innovativi.
La ricerca suggerisce dunque che la resistenza agli antibiotici non sia soltanto una conseguenza dell’abuso moderno di farmaci, ma un fenomeno radicato nella storia evolutiva dei batteri. Comprendere questi meccanismi ancestrali potrebbe rivelarsi decisivo per affrontare una delle più complesse sfide della medicina contemporanea.